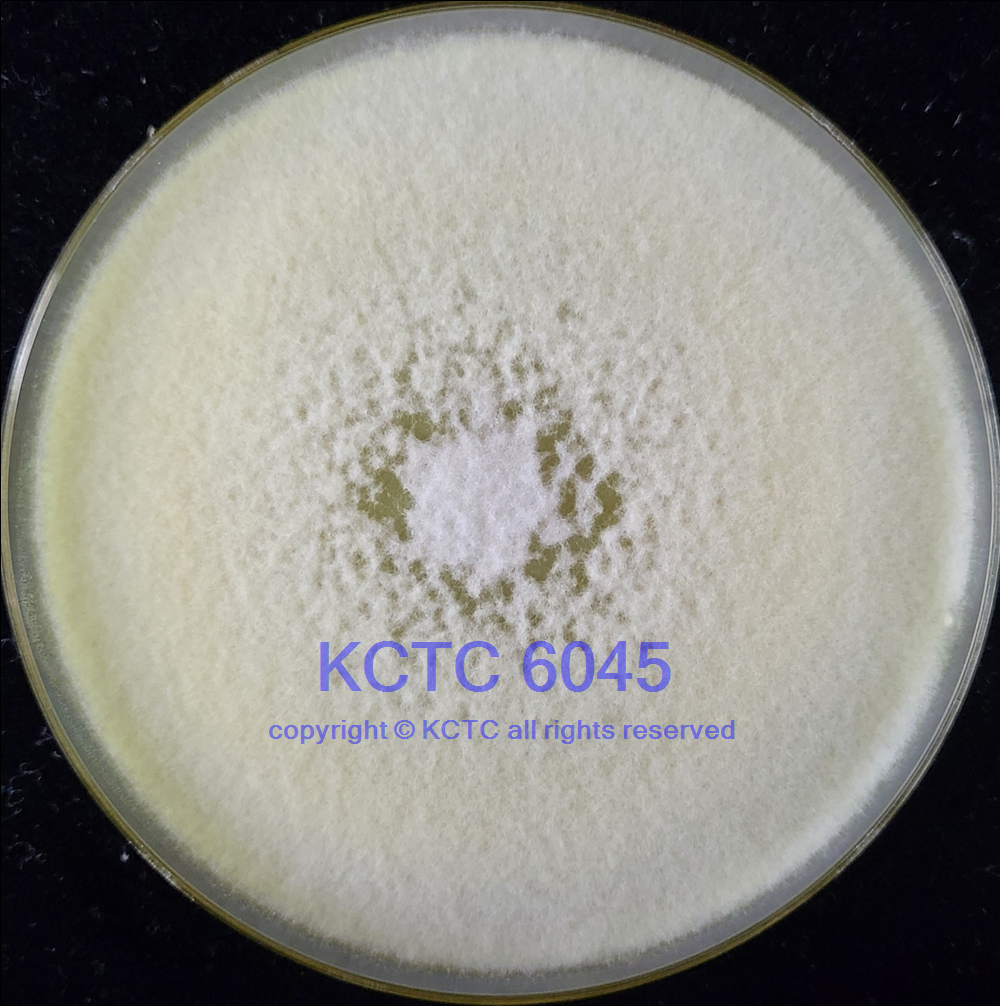

Name:
Trichoderma reesei Simmons
DSM No.:
770
Strain designation:
178, QM 9136
Other collection no.
or WDCM no.:
ATCC 26920 KCTC No.6045
Country:
country of origin unknown
Date of sampling:
before 03.11.1976
Nagoya Protocol Restrictions:
There are NO known Nagoya Protocol restrictions for this strain.
History:
<- QM, 9136 <- M. Mandels, 178
Cultivation conditions:
Medium 129 , 24°C
Complete DSMZ Media List
Summary and
additional information:
<- QM, 9136 <- M. Mandels, 178. Formerly known as T. reesei. Mutant of QM 6a (DSM 768), cellulase negative (1058). (Medium 129, 24°C)
Literature:
1058
Risk group:
1 (classification according to German TRBA)
Supplied as:
Delivery form Prices
Price Category for this culture: 1
Freight and handling charges will be added. See price list.
Other cultures:
All DSMZ cultures of the species
Print data sheet
DSM770